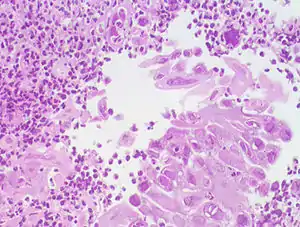

Езофагіт
Езофагі́т (лат. oesophagitis; oesophagus стравохід + лат. -itis) — запалення слизової стравоходу.
| Езофагіт | |
|---|---|
![]() Езофагіт, яки спричинив вірус герпесу Езофагіт, яки спричинив вірус герпесу | |
| Спеціальність | гастроентерологія |
| Препарати | Езомепразол[1][2], Лансопразол[1], Омепразол[1][2], Пантопразол[1][2], sucralfated[1], Деносумаб[2], pantoprazole sodiumd[3] і Декслансопразол[4] |
| Класифікація та зовнішні ресурси | |
| МКХ-11 | DA24 |
| МКХ-10 | K20 |
| DiseasesDB | 9182 |
| MeSH | D004941 |
| | |
За клінічним перебігом розрізняють гострі, підгострі та хронічні езофагіти.
Клінічні ознаки
Клінічний перебіг захворювання визначається гостротою, етіологією та поширеністю процесу. Гострий катаральний езофагіт проявляється болем при ковтанні, відчуттям садження за грудниною, іноді дисфагією. При геморагічному езофагіті спостерігають гематемезис (криваве блювання) та рідше криваві випорожнення — мелена. Тяжко, з проявами сепсису перебігає абсцес та флегмона стравоходу.
Різновиди
Гострий езофагіт
Гострий езофагіт розвивається внаслідок механічного та термічного пошкодження слизової оболонки стравоходу, а також при деяких інфекційних хворобах.
Хворі відмічають біль і порушення проходження їжі по стравоходу, блювоту з виділенням в'язкого слизу, іноді з домішками крові. Може бути гарячка. Гострий езофагіт може ускладнюватися перфорацією, кровотечею, гнійним медіастинітом.
Лікування
У легких випадках хворі повинні пити маленькими ковтками холодне молоко або ковтати шматочки льоду. У більш тяжких випадках рекомендують утримуватися від прийому їжі упродовж 2-3 днів, у подальшому призначають достатньо калорійну та вітамінізовану, механічно та хімічно щадну дієту. З медикаментозних засобів застосовують за необхідності антибіотики, протиспастичні (папаверин, платифілін) та болезаспокійливі препарати. При блюванні показаний анестезин або новокаїн всередину.
Хронічний езофагіт
Хронічний езофагіт може бути виходом гострого, в інших випадках він супутній місцевим ураженням, наприклад при грижі стравохідного отвору діафрагми. Причинами захворювання можуть бути також вітамінна недостатність (вітаміни В, А, С), зловживання алкоголем. Хронічні езофагіти спостерігають у хворих на хронічні інфекційні захворювання — туберкульоз, сифіліс, ВІЛ-інфекція тощо. Можуть з'явитися застійні езофагіти у хворих стенозом стравоходу, ахалазією кардії. Найчастішою причиною є рефлюкс-езофагіт (пептичний езофагіт).
Захворювання проявляється відчуттям важкості та нерізкого болю за ходом стравоходу, відрижкою, печією. Важливе діагностичне значення має езофагоскопія, яка дозволяє виключити новоутворення.
Лікування
Дієта з виключенням гострої, грубої, гарячої їжі. Забороняється споживання спиртних напоїв та паління. Призначають також спазмолітичні та лужні засоби, як при пептичній виразці шлунку. Сприятливо діють мінеральні води.
Примітки
- NDF-RT
- Drug Indications Extracted from FAERS — doi:10.5281/ZENODO.1435999
- Inxight: Drugs Database
- Inxight: Drugs Database
Джерела
- Довідник фельдшера/під ред. А. Н. Шабанова. — 4-е вид., стереотип. — М.: Медицина, 1984.
- Довідник дільничого терапевта по фармакотерапії/під ред. М. В. Бочкарьова та Є. А. Мухіна. — Кишинів: Картя молдовеняске, 1986.